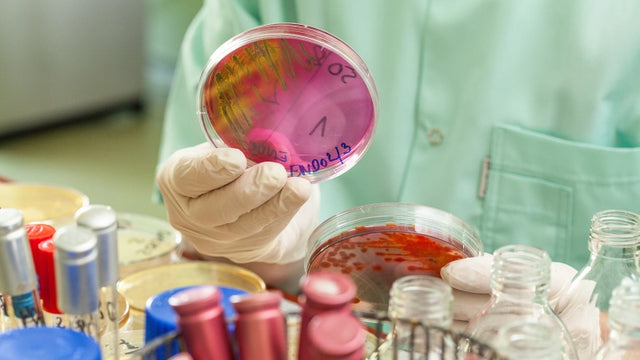

दवा और संबंधित उद्योगों में MF0334-3 पाठ्यक्रम संगठन

Request information


Syllabus
Download syllabus in PDFCurriculum
सारांश
रसायन विज्ञान की दुनिया के भीतर, फार्मोकेमिस्ट्री के पेशेवर क्षेत्र के भीतर दवा और संबंधित उत्पादों के निर्माण के विभिन्न क्षेत्रों को जानना आवश्यक है। इस प्रकार, इस पाठ्यक्रम का उद्देश्य दवा और संबंधित उद्योगों में संगठन के बारे में आवश्यक ज्ञान प्रदान करना है।
लक्ष्य
व्यावसायिक अवसर
तुम्हें तैयार करने के लिए
इस गठन को दवा और संबंधित उद्योगों में MF0334_3 संगठन के प्रशिक्षण यात्रा कार्यक्रम में समायोजित किया जाता है, जिसमें शामिल विभिन्न प्रतिस्पर्धा इकाइयों को पार करने के लिए प्रमाणित किया जाता है, और इसका उद्देश्य काम के अनुभव के माध्यम से प्राप्त पेशेवर प्रतिस्पर्धाओं की मान्यता (जो स्वयं के लिए स्वायत्तता के रूप में काम करना है, जो कि संबंधित स्वायत्तता के रूप में काम कर रहे हैं, 18 जुलाई के डिक्री 659/2023, जो पेशेवर प्रशिक्षण प्रणाली के प्रबंधन को विकसित करता है और कार्य अनुभव या गैर -सूचना प्रशिक्षण द्वारा प्राप्त पेशेवर प्रतिस्पर्धाओं की मान्यता के लिए एक स्थायी प्रक्रिया स्थापित करता है)।
यह किसे संबोधित है?
यह पाठ्यक्रम रसायन विज्ञान की दुनिया के पेशेवरों के उद्देश्य से है, विशेष रूप से दवा और संबंधित उत्पादों के निर्माण में, फार्मोकेमिस्ट्री के पेशेवर क्षेत्र के भीतर और उन सभी लोग जो दवा और संबंधित उद्योगों में संगठन से संबंधित ज्ञान प्राप्त करने में रुचि रखते हैं।
आधिकारिक चरित्र
यह प्रशिक्षण आधिकारिक विनियमित प्रशिक्षण (शिशु शिक्षा, प्राथमिक शिक्षा, माध्यमिक शिक्षा, आधिकारिक पेशेवर प्रशिक्षण एफपी, बैकलौरीएट, विश्वविद्यालय की डिग्री, आधिकारिक विश्वविद्यालय मास्टर और पीएचडी) के दायरे में शामिल नहीं है। इसलिए यह एक पूरक और/या विशेषज्ञता प्रशिक्षण है, जिसका उद्देश्य एक पेशेवर प्रकृति के कुछ कौशल, कौशल या योग्यता प्राप्त करना है, जो कि वर्कबैग और/या विपक्षी प्रतियोगिताओं में योग्यता के रूप में मुश्किल से सक्षम है, हमेशा पूरक प्रशिक्षण अनुभाग के भीतर और/या निरंतर प्रशिक्षण हमेशा सार्वजनिक श्रम स्टॉक बाजार के सार्वजनिक श्रम स्टॉक की विशिष्ट आवश्यकताओं की समीक्षा करने के लिए आवश्यक है।

हमारी कार्यप्रणाली आपके अनुरूप सीखने के लिए प्रौद्योगिकी, शिक्षाशास्त्र और सहानुभूति को जोड़ती है।
आप गति निर्धारित करते हैं, रास्ता तय करते हैं और कृत्रिम बुद्धिमत्ता आपका साथ देती है ताकि आप अर्थ और उद्देश्य के साथ बेहतर सीख सकें।

वास्तव में वैयक्तिकृत शिक्षण
आपकी शैली, रुचियां और स्तर मार्ग निर्धारित करते हैं। आप शुरुआती बिंदु हैं.

कार्रवाई में रचनावाद
अन्वेषण करें, प्रयोग करें और लागू करें। सीखने का मतलब समझना है, याद रखना नहीं।

एआई जो आपका साथ देता है, आपको निर्देशित नहीं करता
PHIA, हमारा कृत्रिम बुद्धिमत्ता सहायक आपकी स्वायत्तता को सीमित किए बिना आपका मार्गदर्शन करता है।

बिना दबाव के मूल्यांकन
सतत और अनुकूली प्रतिक्रिया. क्योंकि सीखना एक प्रक्रिया है, कोई संख्या नहीं।
Certification

31 अक्टूबर को रॉयल डिक्री 1534/2011 में विनियमित फार्मास्युटिकल एंड संबंधित उद्योगों में प्रशिक्षण मॉड्यूल MF0334_3 संगठन में एकत्र की गई क्षमता इकाइयों को मान्यता देने वाले गैर -सूचना प्रशिक्षण को पार करने की डिग्री, जो व्यावसायिकता के संबंधित प्रमाण पत्र को स्थापित करती है। 22 मार्च, 2022 के निर्देश के अनुसार, जो कार्य अनुभव या प्रशिक्षण के गैर -सूचना मार्गों के माध्यम से अधिग्रहित पेशेवर प्रतिस्पर्धा के मूल्यांकन और मान्यता के लिए प्रक्रिया में भागीदारी के लिए अनुरोध करने वाले व्यक्तियों द्वारा प्रदान किए गए प्रशिक्षण के प्रवेश के लिए मानदंड निर्धारित करता है। EUROINNOVA FACION S.L. यह SEPE संस्थाओं की फ़ाइल, श्रम और सामाजिक अर्थव्यवस्था मंत्रालय की एक भाग लेने वाली इकाई है।

एजुकाहब छात्रवृत्ति
अपने प्रशिक्षण को अधिक सुलभ बनाएं: 0% ब्याज पर वित्त पोषण करें और वैयक्तिकृत छात्रवृत्ति प्राप्त करें।
एजुकाहब में हमारा मानना है कि शिक्षा सभी के लिए उपलब्ध होनी चाहिए। इस कारण से, हम एक छात्रवृत्ति योजना की पेशकश करते हैं जो आर्थिक बाधाओं को दूर करते हुए व्यावहारिक, वर्तमान और गुणवत्तापूर्ण प्रशिक्षण तक आपकी पहुंच को सुविधाजनक बनाती है।
-25%
पूर्व छात्र छात्रवृत्ति: पूर्व एजुकाहब छात्रों के लिए।
-20%
बेरोजगारी छात्रवृत्ति: यदि आप साबित करते हैं कि आप बेरोजगार हैं।
-20%
बड़े परिवार की छात्रवृत्ति: 3 या अधिक बच्चों वाले परिवारों के लिए।
-20%
विकलांगता छात्रवृत्ति: विकलांग लोगों के लिए ≥33%।
-15%
एम्प्रेन्डे छात्रवृत्ति: स्व-रोज़गार श्रमिकों के लिए जो अपनी गतिविधि साबित कर सकते हैं।
-15%
अनुशंसित छात्रवृत्ति: यदि आप किसी पूर्व छात्र द्वारा अनुशंसित हैं।
-15%
समूह छात्रवृत्ति: 3 या अधिक लोगों के संयुक्त पंजीकरण के लिए।

एक संपूर्ण शैक्षिक जगत, एक ही मंच पर।
एआई के साथ एक सहज ज्ञान युक्त वातावरण जो आपको स्वायत्त रूप से और उद्देश्य के साथ प्रशिक्षित करने के लिए मार्गदर्शन करता है।

अपनी गति से सीखें
पाठ्यक्रम, मास्टर डिग्री और आधिकारिक योग्यताएँ। 100% ऑनलाइन, लचीला और आपकी गति से।

कहीं से भी प्रवेश
मोबाइल, टैबलेट या पीसी पर 24/7 उपलब्ध है। आप तय करें कि कब और कैसे प्रशिक्षण लेना है।

फिया, आपकी एआई गुरु
यह आपको चुनौती देता है, आपको प्रेरित करता है और आपके पथ को वैयक्तिकृत करता है। उस मार्गदर्शक से सीखें जो आपके साथ विकसित होता है।

एलएक्स वन प्लस: बिना किसी सीमा के प्रशिक्षण
सॉफ्ट स्किल्स, भाषाएं और बहुत कुछ अनलॉक करें। व्यापक एवं सतत प्रशिक्षण की ओर बढ़ें।